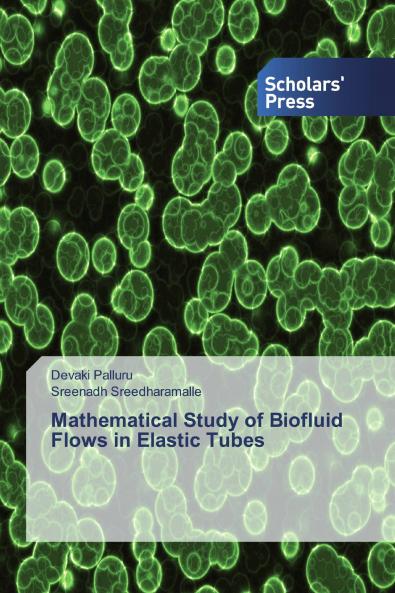
Mathematical Study of Biofluid Flows in Elastic Tubes

English
Paperback
₹6299
(All inclusive*)
Delivery Options
Please enter pincode to check delivery time.
*COD & Shipping Charges may apply on certain items.
Review final details at checkout.
Looking to place a bulk order? SUBMIT DETAILS
Delivery Options
Please enter pincode to check delivery time.
*COD & Shipping Charges may apply on certain items.
Review final details at checkout.
About The Book
Description
Author
This book helps young researchers in the field of biofluid dynamics to acquire knowledge on the flow of Newtonian/ non- Newtonian fluids in an elastic tube including the effect of peristaltic wave transformation. This book creates interest to develop many new mathematical models in elastic tubes which finds its applications in medicine industry and engineering. According to the book the fluids are considered as blood and tubes as arteries vines and capillaries. The results of each problems show how blood flow is affected in different physiological situations.
Details
ISBN 13
9786138840039
Publication Date
-16-07-2019
Pages
-104
Weight
-153 grams
Dimensions
-150x220x5.94 mm